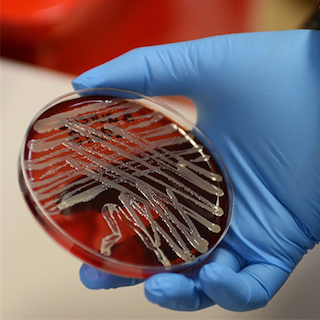
Biomedical & Pharmaceutical Sciences

Biomedical & Pharmaceutical Sciences
DEVELOP THE DIFFERENCE
Contribute to novel research, technologies, and drug development in one of our graduate programs in the biomedical and pharmaceutical sciences. Students studying medicinal chemistry, pharmaceutical sciences and drug design, and toxicology are helping design novel drugs and vaccines and leveraging genomics to personalize medical therapies. Learn in the labs of well-funded and prominent researchers, and leave with the skills needed to pursue work in academia, regulatory agencies, or the pharmaceutical industry.
in research grant funding
of graduates are employed in field
publications per year
Programs
- Medicinal Chemistry Master's Doctorate/Specialist
- Pharmaceutical Sciences & Drug Design Master's Doctorate/Specialist
- Toxicology Master's Doctorate/Specialist
- Pharmaceutical Sciences, Non-Professional Bachelor's


Testing therapies for a healthier future.
Get involved in research on precision medicine, vaccine development and nanotechnologies designed to respond to the health care issues of today.
Research Highlights
SEE MORE RESEARCH

You spin me right round
Our graduates go on to positions in academia, industry, government agencies and spin-off companies like DermaXon - a drug discovery company founded by faculty in our program and located right here in Missoula.




